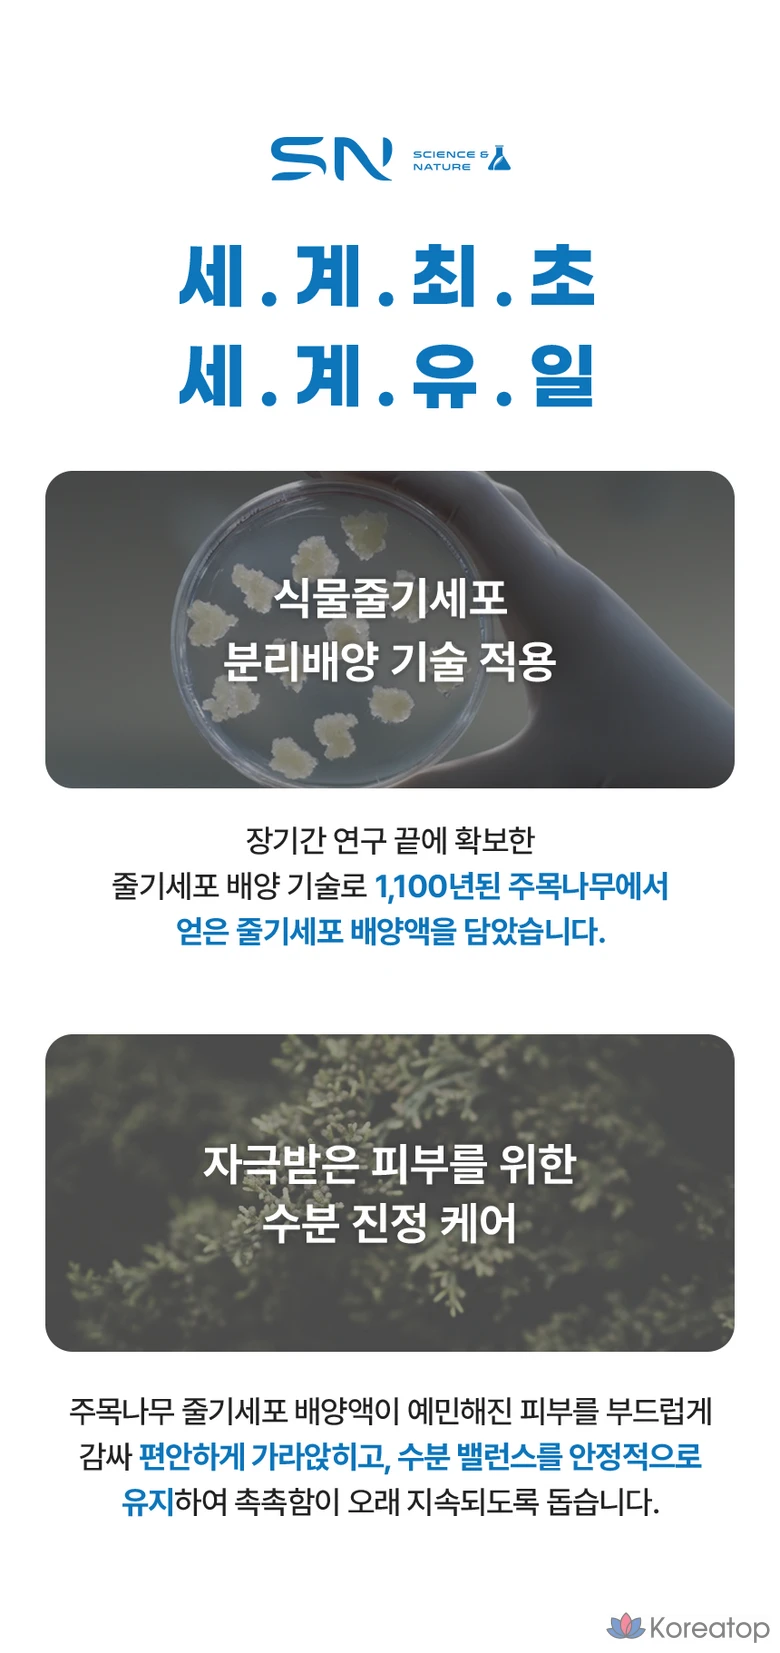

Крем для лица Ongredients SN Skin Tea Cream, 50 мл, 1 шт.
Вам также может понравиться
крем для лица
для всех типов кожи, особенно для уставшей и обезвоженной
экстракт стволовых клеток тисового дерева, экстракт портулака, экстракт центеллы азиатской, гиалуроновая кислота, биосахаридная камедь-1
глубокое увлажнение, успокаивающий эффект, повышение эластичности, восстановление, защита кожи
Подарите коже глоток живительной влаги и спокойствия с кремом SN Skin Tea Cream. Его насыщенная, бархатистая текстура тает при соприкосновении с кожей, быстро впитываясь без ощущения жирности. В основе формулы — уникальный комплекс растительных экстрактов и стволовых клеток, направленный на глубокое увлажнение и восстановление. Крем эффективно успокаивает раздраженную кожу, поддерживает гидролипидный баланс и повышает эластичность. Результат — невероятно мягкая, гладкая и сияющая кожа, защищенная от стресса и обезвоживания.
















 Telegram
Telegram Вконтакте
Вконтакте Max
Max